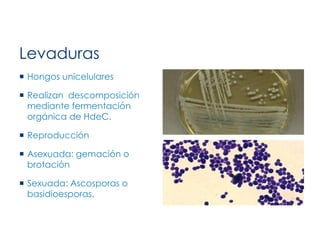
Levaduras
 Hongos unicelulares
 Realizan descomposición
mediante fermentación
orgánica de HdeC.
 Reproducción
 Asexuada: gemación o
brotación
 Sexuada: Ascosporas o
basidioesporas.

Este documento describe las características generales de los hongos. Explica que los hongos pertenecen al reino Fungi y que se reproducen tanto sexualmente como asexualmente mediante esporas. También describe las estructuras fúngicas como las hifas, micelios y levaduras, y los diferentes tipos de esporas como conidios, ascospores y basidiosporas.